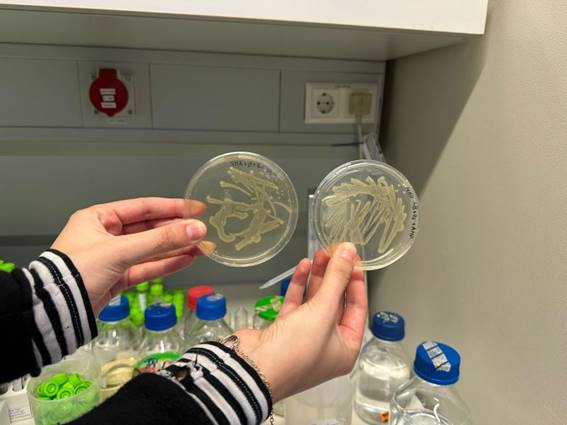

DIG4BIO Training School: Innovation in Action at TU Berlin
🤖 DIG4BIO Training School: Innovation in Action at TU Berlin!
From October 27–30, 2025, the DIG4BIO Training School – “An Introduction to Automated Research” gathered participants from IST and IST-ID at TU Berlin for an inspiring 4-day deep dive into the world of automation, robotic laboratories, and digital biomanufacturing.
👩🔬 Guided by Prof. Peter Neubauer, Rosa Haßfurther, Nicolas Cruz, and Annina Kemmer, participants explored how high-throughput experimentation, and advanced data analytics are transforming modern biotechnology — from small-scale design to industrial applications.
🧠 Days 1–2: Participants defined research hypotheses and experimental goals, shaping the concept for a collaborative manuscript on Vibrio natriegens cultivation.
⚙️ Days 3–4: Theory met practice — with 24 fermentations in mini bioreactors performed on TU Berlin’s 2mag platform, combining automation, real-time analytics, and teamwork in true DIG4BIO fashion.
💬 This immersive experience strengthened cooperation between European partners and showcased how digital tools and robotics are paving the way for next-generation biomanufacturing.
✨ Automating discovery. Advancing digital biotech. ✨
👏 Acknowledgments:
We are deeply grateful to the European Research Executive Agency (REA) and EU Science, Research and Innovation.
Funded by the European Union. Views and opinions expressed are however those of the author(s) only and do not necessarily reflect those of the European Union or the European Research Executive Agency (REA).
#DIG4BIO #TUBerlin #IST #IST-ID #TrainingSchool #DigitalBiomanufacturing #Automation #Bioprocessing #HorizonEU #ResearchImpactEU #EUInnovation